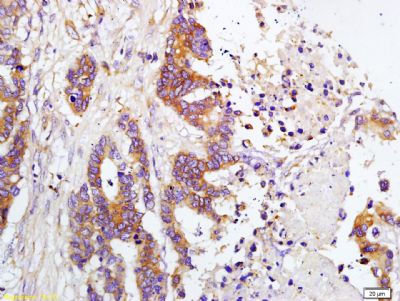
TIMP-1 antibody
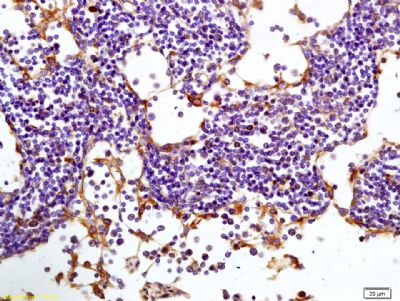
TIMP-1 antibody

相关产品推荐更多 >
万千商家帮你免费找货
0 人在求购买到急需产品
- 详细信息
- 技术资料
- 供应商:
上海康朗生物科技有限公司
- 库存:
大量
- 目录编号:
kl-0415R
- 克隆性:
多克隆
- 抗原来源:
Rabbit
- 保质期:
12个月
- 抗体英文名:
TIMP-1 antibody
- 抗体名:
金属蛋白酶组织抑制因子-1抗体
- 宿主:
Rabbit
- 适应物种:
Human, Mouse, Rat, Dog, Pig, Cow, Rabbit, Sheep,
- 免疫原:
KLH conjugated synthetic peptide derived from human TIMP-1:103-207/207
- 亚型:
IgG
- 形态:
冻干粉或液体
- 应用范围:
WB=1:500-2000 ELISA=1:500-1000 IHC-P=1:400-800 IHC-F=1:400-800 IF=1:100-500
- 浓度:
1mg/ml
- 保存条件:
-20 °C
- 规格:
50ul 100ul 200ul
TIMP-1 antibody
| 中文名称 | 金属蛋白酶组织抑制因子-1抗体 |
| 别 名 | Clgi; Collagenase inhibitor; EPA; EPO; Erythroid Potentiating Activity; Fibroblast collagenase inhibitor; FLJ90373; HC; Human Collagenase Inhibitor; Metalloproteinase inhibitor 1; Metalloproteinase inhibitor 1 precursor; OTTHUMP00000023214; TIMP 1; TIMP; TIMP metallopeptidase inhibitor 1; TIMP1 protein; Tissue Inhibitor of Metalloproteinase 1; Tissue inhibitor of metalloproteinases; Ttissue inhibitor of metalloproteinase 1 erythroid potentiating activity collagenase inhibitor. |
![]() |
Specific References (8) | bs-0415R has been referenced in 8 publications. [IF=3.56] Sassoli, Chiara, et al. "Defining the role of mesenchymal stromal cells on the regulation of matrix metalloproteinases in skeletal muscle cells." Experimental Cell Research (2014). Mouse. PubMed:24631289 [IF=3.53] Lu HY, Huang CY, Shih CM, Chang WH, Tsai CS, et al. (2015) Dipeptidyl Peptidase-4 Inhibitor Decreases Abdominal Aortic Aneurysm Formation through GLP-1-Dependent Monocytic Activity in Mice. PLoS ONE 10(4): e0121077. IHC-P ; Mouse. PubMed:25876091 [IF=2.53] Ni, Wei-Jian, et al. "Renoprotective effects of berberine through regulation of the MMPs/TIMPs system in streptozocin-induced diabetic nephropathy in rats."European Journal of Pharmacology (2015). WB ; Rat. PubMed:26192633 [IF=3.31] Watts, Ryan P., et al. "Novel 24-h ovine model of brain death to study the profile of the endothelin axis during cardiopulmonary injury." Intensive Care Medicine Experimental 3.1 (2015): 31. IHC-P ; PubMed:26596583 [IF=2.62] Sassoli, Chiara, et al. "Low intensity 635 nm diode laser irradiation inhibits fibroblast–myofibroblast transition reducing TRPC1 channel expression/activity: New perspectives for tissue fibrosis treatment." Lasers in Surgery and Medicine (2016). Mouse. PubMed:26660509 [IF=2.14] Lu, Minling, et al. "The effects of mycotoxins and selenium deficiency on tissue-engineered cartilage." Cells Tissues Organs 196.3 (2012): 241-250. IHC-P ; Rabbit. PubMed:22538829 [IF=3.14] Varghese, Sheeja, et al. "The inhibitory effect of anti-tumor polysaccharide from Punica granatum on metastasis." International Journal of Biological Macromolecules (2017). WB ; Human. PubMed:28552725 [IF=1.26] Jiang, Li, Tongfu Zhou, and Hanming Liu. "Combined effects of the ATP-sensitive potassium channel opener pinacidil and simvastatin on pulmonary vascular remodeling in rats with monocrotaline-induced pulmonary arterial hypertension." Die Pharmazie-An International Journal of Pharmaceutical Sciences 67.6 (2012): 547-552. IHC-P ; Rat. PubMed:22822545 |
| 规格价格 | 50ul/780元 购买 100ul/1380元 购买 200ul/2200元 购买 大包装/询价 |
| 说 明 书 | 50ul 100ul 200ul |
| 研究领域 | 肿瘤 细胞生物 神经生物学 细胞凋亡 生长因子和激素 激酶和磷酸酶 合成与降解 |
| 抗体来源 | Rabbit |
| 克隆类型 | Polyclonal |
| 交叉反应 | Human, Mouse, Rat, Dog, Pig, Cow, Rabbit, Sheep, |
| 产品应用 | WB=1:500-2000 ELISA=1:500-1000 IHC-P=1:400-800 IHC-F=1:400-800 IF=1:100-500 (石蜡切片需做抗原修复) not yet tested in other applications. optimal dilutions/concentrations should be determined by the end user. |
| 分 子 量 | 21kDa |
| 细胞定位 | 分泌型蛋白 |
| 性 状 | Lyophilized or Liquid |
| 浓 度 | 1mg/ml |
| 免 疫 原 | KLH conjugated synthetic peptide derived from human TIMP-1:103-207/207 |
| 亚 型 | IgG |
| 纯化方法 | affinity purified by Protein A |
| 储 存 液 | 0.01M TBS(pH7.4) with 1% BSA, 0.03% Proclin300 and 50% Glycerol. |
| 保存条件 | Store at -20 °C for one year. Avoid repeated freeze/thaw cycles. The lyophilized antibody is stable at room temperature for at least one month and for greater than a year when kept at -20°C. When reconstituted in sterile pH 7.4 0.01M PBS or diluent of antibody the antibody is stable for at least two weeks at 2-4 °C. |
| PubMed | PubMed |
| 产品介绍 | background: This gene belongs to the TIMP gene family. The proteins encoded by this gene family are natural inhibitors of the matrix metalloproteinases (MMPs), a group of peptidases involved in degradation of the extracellular matrix. In addition to its inhibitory role against most of the known MMPs, the encoded protein is able to promote cell proliferation in a wide range of cell types, and may also have an anti-apoptotic function. Transcription of this gene is highly inducible in response to many cytokines and hormones. In addition, the expression from some but not all inactive X chromosomes suggests that this gene inactivation is polymorphic in human females. This gene is located within intron 6 of the synapsin I gene and is transcribed in the opposite direction. [provided by RefSeq]. Function: Complexes with metalloproteinases (such as collagenases) and irreversibly inactivates them by binding to their catalytic zinc cofactor. Also mediates erythropoiesis in vitro; but, unlike IL-3, it is species-specific, stimulating the growth and differentiation of only human and murine erythroid progenitors. Known to act on MMP-1, MMP-2, MMP-3, MMP-7, MMP-8, MMP-9, MMP-10, MMP-11, MMP-12, MMP-13 and MMP-16. Does not act on MMP-14. Subcellular Location: Secreted. Post-translational modifications: The activity of TIMP1 is dependent on the presence of disulfide bonds. Similarity: Belongs to the protease inhibitor I35 (TIMP) family. Contains 1 NTR domain. SWISS: P01033 Gene ID: 7076 Database links: Entrez Gene: 7076 Human Entrez Gene: 21857 Mouse Omim: 305370 Human SwissProt: P01033 Human SwissProt: P12032 Mouse Unigene: 522632 Human Unigene: 8245 Mouse Important Note: This product as supplied is intended for research use only, not for use in human, therapeutic or diagnostic applications. 合成与降解(Synthesis and Degradation) TIMP1是基质金属蛋白酶的抑制酶,其功能与MMP相反,能抑制肿瘤细胞的浸润和转移,主要用于各种恶性肿瘤如乳腺癌等的研究。TIMP-1是一种28kDa的糖蛋白,主要分泌细胞为多种结缔组织细胞,被认为是组织中MMPs活性的主要调节者,它可以和MMPs家族成员以共价键方式形成1:1的复合物,从而发挥其抑制作用。在正常生理条件下,MMPs和TIMPs之间的平衡状态是维持细胞外基质正常状态所必需的,一旦它们之间的比例失调,就会造成一系列的病理状态。 |
| 产品图片 | ![]() Sample: Lane1: Brain(Mouse) Lysate at 30 ug Lane2: Liver (Mouse) Lysate at 30 ug Primary: Anti-TIMP-1 (bs-0415R) at 1:200 dilution; Secondary: HRP conjugated Goat Anti-Rabbit IgG(bs-0295G-HRP) at 1: 3000 dilution; Predicted band size : 21kD Observed band size : 26kD ![]() Tissue/cell: human gastric carcinoma; 4% Paraformaldehyde-fixed and paraffin-embedded; Antigen retrieval: citrate buffer ( 0.01M, pH 6.0 ), Boiling bathing for 15min; Block endogenous peroxidase by 3% Hydrogen peroxide for 30min; Blocking buffer (normal goat serum,C-0005) at 37℃ for 20 min; Incubation: Anti-TIMP-1 Polyclonal Antibody, Unconjugated(bs-0415R) 1:200, overnight at 4°C, followed by conjugation to the secondary antibody(SP-0023) and DAB(C-0010) staining ![]() Tissue/cell: human colon carcinoma; 4% Paraformaldehyde-fixed and paraffin-embedded; Antigen retrieval: citrate buffer ( 0.01M, pH 6.0 ), Boiling bathing for 15min; Block endogenous peroxidase by 3% Hydrogen peroxide for 30min; Blocking buffer (normal goat serum,C-0005) at 37℃ for 20 min; Incubation: Anti-TIMP-1 Polyclonal Antibody, Unconjugated(bs-0415R) 1:200, overnight at 4°C, followed by conjugation to the secondary antibody(SP-0023) and DAB(C-0010) staining ![]() Tissue/cell: human colon carcinoma; 4% Paraformaldehyde-fixed and paraffin-embedded; Antigen retrieval: citrate buffer ( 0.01M, pH 6.0 ), Boiling bathing for 15min; Block endogenous peroxidase by 3% Hydrogen peroxide for 30min; Blocking buffer (normal goat serum,C-0005) at 37℃ for 20 min; Incubation: Anti-TIMP-1 Polyclonal Antibody, Unconjugated(bs-0415R) 1:200, overnight at 4°C, followed by conjugation to the secondary antibody(SP-0023) and DAB(C-0010) staining ![]() Tissue/cell: rabbit liver tissue; 4% Paraformaldehyde-fixed and paraffin-embedded; Antigen retrieval: citrate buffer ( 0.01M, pH 6.0 ), Boiling bathing for 15min; Block endogenous peroxidase by 3% Hydrogen peroxide for 30min; Blocking buffer (normal goat serum,C-0005) at 37℃ for 20 min; Incubation: Anti-TIMP-1 Polyclonal Antibody, Unconjugated(bs-0415R) 1:200, overnight at 4°C, followed by conjugation to the secondary antibody(SP-0023) and DAB(C-0010) staining |
风险提示:丁香通仅作为第三方平台,为商家信息发布提供平台空间。用户咨询产品时请注意保护个人信息及财产安全,合理判断,谨慎选购商品,商家和用户对交易行为负责。对于医疗器械类产品,请先查证核实企业经营资质和医疗器械产品注册证情况。
技术资料暂无技术资料 索取技术资料
TIMP-1 antibody
¥780 - 2200